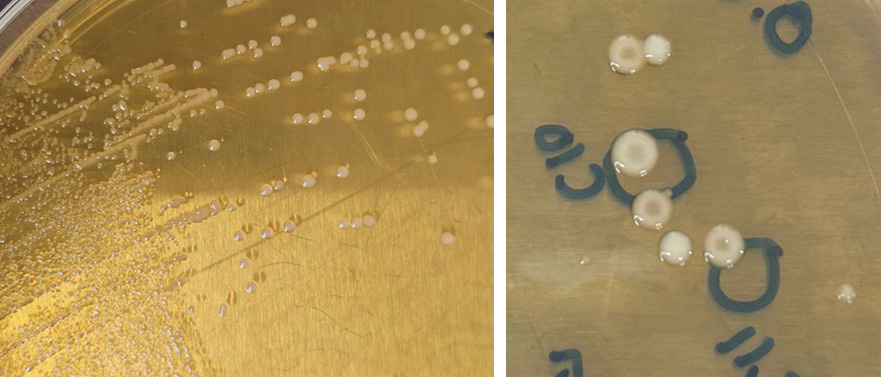
. Left- Healthy wild type L. mesenteroides. Right- After exposure, recovered mutants expressing center indention

Background
Global demand for sustainable food production is rising as population growth collides with limits on arable land. Microbial fermentation plays a critical role in meeting this demand, not only in food manufacturing but also in sectors such as pharmaceuticals, fuels, and materials. To improve microbial performance, industry commonly employs random mutagenesis techniques, such as UV irradiation or chemical mutagens. These approaches are attractive because they allow products to retain a non-GMO label, but they suffer from limitations: chemical mutagens can be hazardous, and UV light cannot reliably reach deep into genomes to produce all potential beneficial mutations.
Figure 1: Observed changes to the colony phenotypic morphology after plasma exposure. Left (Fig. 1a): Healthy wild type L. mesenteroides. Right: (Fig. 1b): After exposure, recovered mutants expressing center indention.
Plasma mutagenesis is emerging as a superior alternative. Atmospheric and room-temperature plasmas (ARTP) generate a rich mixture of ions, radicals, and reactive oxygen and nitrogen species, enabling broader and deeper genome-level mutations. These changes activate microbial stress-response systems that often lead to beneficial random mutations. Prior studies show that ARTP can enhance tolerance, enzyme activity, and production traits in various microbial species.

Figure 2: Processing of plasma exposed microbes.
This project applies plasma mutagenesis to Leuconostoc mesenteroides, a lactic acid bacterium widely used in dairy and fermented foods. This microbe tends to prefer sucrose and glucose over fructose, leaving excess fructose in products, which negatively impacts flavor and increases secondary processing costs. By promoting mutations that enhance fructose utilization, the project aims to improve flavor, reduce costs, and expand the utility of plasma mutagenesis as a tool for microbial optimization.
Approach
The objective of this project is to demonstrate that exposure to atmospheric and room temperature plasma can produce beneficial mutations in Leuconostoc mesenteroides, specifically within the genes that affect fructose metabolism. By enabling the bacterium to utilize fructose more efficiently, the project seeks to improve flavor profiles in food products and reduce manufacturing costs associated with removing excess fructose.

Figure 3: Plasma exposure to microbes inoculated within a droplet on top of a 5mm glass coupon.
To achieve this objective, the research began with characterizing the wild type strain of L. mesenteroides to establish baseline data for growth curves, genomic sequence, and fructose metabolism. This provides a reference point for evaluating the performance of mutant strains. The next step involved exposing bacterial cultures to plasma under varying conditions that altered gas type, gas flow, power level, exposure time, and distance of source to substrate. Kill curves were created to identify the plasma parameters that result in ten to twenty percent survival, which is expected to yield the highest probability of beneficial mutations.
Mutant strains that survive plasma exposure are then evaluated for improved fructose uptake using growth and metabolic assays within a reduced fructose media. The survivors chosen for further analysis are those that show increased proliferation over the wild type amongst the restricted fructose media. DNA sequencing and bioinformatics are performed to identify where mutations occur and to determine whether they are associated with genes such as adhE and the phosphotransferase system, which play critical roles in carbohydrate metabolism. These plasma-induced mutants are also compared to strains generated through ultraviolet light mutagenesis to highlight the advantages of plasma as a tool for inducing deeper and more diverse mutations.
Finally, the study incorporates a repeatability assessment to evaluate whether beneficial mutations can be consistently reproduced. Multiple rounds of plasma exposure are conducted to confirm whether similar or functionally equivalent mutations arise across trials, thereby establishing the reliability of the technique. Through this systematic approach, the project aims to validate plasma mutagenesis as a scalable and superior method for improving microbial performance in food and related industries.

Figure 4: Mutants versus the wild type strain, all showing increased propagation and perseverance within the minimal fructose media.
Accomplishments
Initially, we were able to establish steady and interval-derived growth curves for L. mesenteroides demonstrating a preference for its Lactobacilli MRS media containing 20 grams of Dextrose. Any media containing both dextrose and fructose illustrated a quicker exponential rise but also plummeted to stationary phase much quicker than the steady state growth observed with just the presence of dextrose, thus indicating the struggle to fully metabolize the additional sugar (fructose).
Plasma exposure testing has been conducted using both argon gas and a combination of air and argon balance. Additionally, testing has been conducted at varying gas flow rates, for different times of exposure, varying source-to-substrate distances and with the bacterial droplet as a wet and dry inoculum.
A secondary screening method was developed to determine whether surviving mutants showcased increase utilization of a very low concentration of fructose (0.05% weight) over the wild type. The growth absorbance at 600nm for the wild type is stagnant at 6 hours post inoculation, therefore, any mutants that showcase increased stability during these 6 hours, have higher and sustained absorbance and that do not have a crashing exponential phase, are selected for DNA extraction and sequencing review. Plasma mutants, controls and UV exposed bacteria are all undergoing bioinformatic screening. Out of the several metabolic genes of interest, mutations are occurring during plasma exposure. Some of the high frequency mutations have a clear advantage over the wild type seen through secondary screening. Some of the reoccurring mutations are seen across plasma treated samples. At this point, the next step is to understand which mutations are conserved versus unique to plasma treatment and whether are not those beneficial changes are repeatable.

Figure 5: Distribution of mutations for plasma mutagenesis treatment and UV controls. Mutations for each sample was determined after screening twice with a modified MRS media containing 0.05% fructose and no glucose. Screening was used to determine whether the sample displayed improved growth over the WT L. mesenteroides ATCC 8293 and samples that did, were sent for genome sequencing using an MiSeq FGx table-top sequencer. Mutation position columns (columns beginning after Test Time) marked with dotting are mutations found in a collection of controls, regardless of if the mutation was present in the select dates starting culture. The color coding for this chart is: Red = High Impact Mutation, Yellow = Moderate Impact Mutation, Green = Low Impact Mutation, and Blue = Modifier Mutation. Note: The plasma mutagenesis treatment on 06/12/2025 was an Argon/Air plasma treatment with a 310 sccm Argon and 280 sccm Air plasma stream at 1cm s2s.
